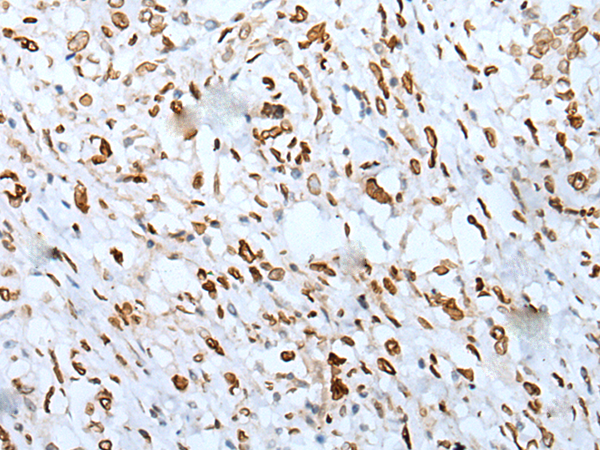
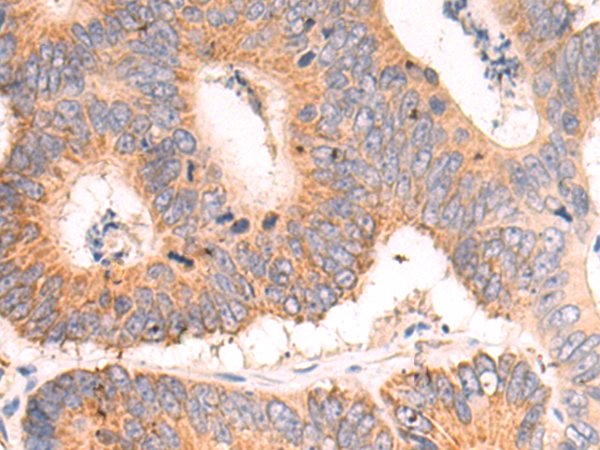
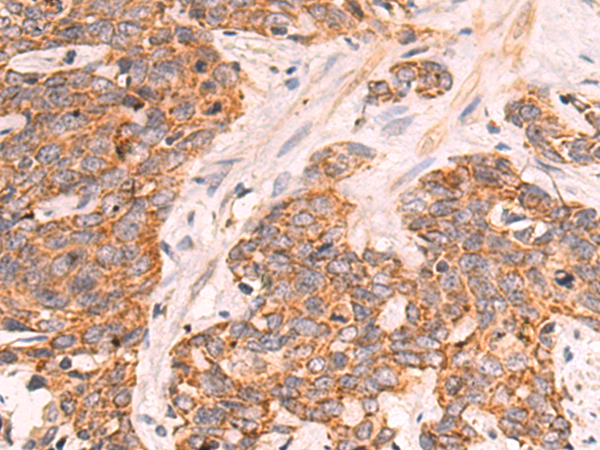
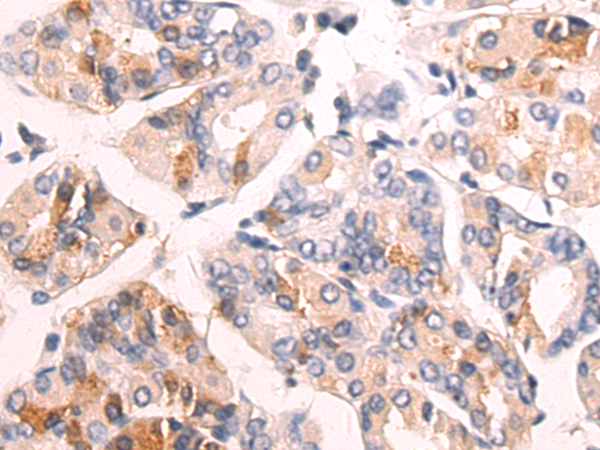

-
分类: 科研抗体货号: P04166别名: HUP48应用: WB反应种属: Human, Mouse
-
分类: 科研抗体货号: P04080别名: LIG3应用: IHC反应种属: Human
-
分类: 科研抗体货号: P04103别名: PIF; C15orf20应用: WB,IHC反应种属: Human, Mouse
-
分类: 科研抗体货号: P04149别名: NR3; MRD6; NR2B; hNR3; DEE27; EIEE27; GluN2B; NMDAR2B应用: WB,IHC反应种属: Human, Mouse, Rat
-
分类: 科研抗体货号: P04165别名:应用: WB,IHC反应种属: Human, Mouse, Rat
-
分类: 科研抗体货号: P04102别名: FMS, CSFR, FIM2, HDLS, C-FMS, CD115, CSF-1R, M-CSF-R应用: IHC反应种属: Human, Mouse, Rat
-
分类: 科研抗体货号: P04146别名: NTR2应用: WB反应种属: Human, Mouse
-
分类: 科研抗体货号: P04164别名: PAR4, Par-4应用: WB,IHC反应种属: Human
-
分类: 科研抗体货号: P04098别名: MCT; HHF7; MCT1; MCT1D应用: WB,IHC反应种属: Human
-
分类: 科研抗体货号: P04163别名: TR; HTR; CF2R; PAR1; PAR-1应用: IHC反应种属: Human

鄂公网安备42018502007531号
鄂公网安备42018502007531号

